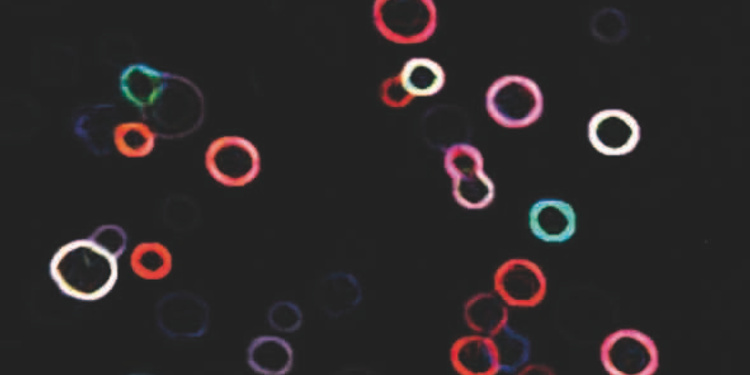

Trio à l'entrepôt

⚡ 👉🏻👉🏻👉🏻 TOUTES LES INFORMATIONS SONT DISPONIBLES ICI CLIQUEZ 👈🏻👈🏻👈🏻
Le sexe oral amateur et tour rapide
Les jeunes chiennes se laissent emporter
Je ne peux pas m'empêcher de baiser le père de mon ami
Une infirmiere sexy se fist à merveille
Rocky Emerson And Jasmine Grey
Une bonne baise entre ados
Chatte poilue bien pénétrée
Madame aime la baise, elle est servie
Une bifle pour cette acharne de gorge profonde
Chatte charnue d’Estelle, femme au foyer d’Amiens
Une MILF rousse qui adore le sexe
Quatre lesbiennes devant une piscine
Une japonaise coquine se fait bien doigter dans sa sextape perso
Un massage très sexuel.
Janice Griffith Hd
Vibro en solo pour une blonde en POV
Fille plantureuse aime la fête de la saucisse
Sexe Ala Plage
Video Porno 2021
Sexy nina roberts blows like a champion - Video porno films xxx sexe en streaming
Ils ont attrapé le voleur et ils baisent ensemble,
Le prof de sport
Il surprend sa sœur avec un vibro
Isabella va jouer avec une grosse peluche !
Les gros seins sont excellents pour les grosses queues
Jeune cul parfait baise un rappeur
Beurette aux gros boobs à voir en webcam !
Une belle rousse avec une queue dans la bouche
Une brune qui aime nous soumettre
Shemale magnifique enculée
Striptease et baise hardcore d'une blonde sexy
Pipe en POV par ma copine
Un trio familiale, que du bonheur
Une Milf blonde se prend un homme
Une trans latine sexy bien démontée par un africain viril
Devyn Heart baisée par un black en glory hole
Il baise sa mère pendant qu'elle dortbaise l'infirmière excitée
La Série Blonde #41
Une MILF brune se tape son beau fils
Films Porno Gratuit En Francais
Bonasse asiatique niquée par un touriste
Brune, blonde et bite
Blonde au visage angélique touche sa chatte
Première séance anale pour Ariana Marie
Latina en plan à trois
VIDÉOS DE LEXI BELLE POV LES PLUS VUES
Pétasse en bas-résilles enculée devant sa webcam
Brune avec un talent pour sucer des bites
Video Du Jour Jacqueline Et Michel
Etudiante nympho qui adore baiser devant sa fenêtre !
Une vidéo japonaise pour adulte
Une brune parfaite et deux mecs
French officer and secretary fucking very hardly - Video porno films xxx sexe en streaming
Valentina Porn
Milf prête à encaisser une énorme queue noire
Masturbation orgasmique
Une après midi barbecue et partouze - Video porno films xxx sexe en streaming
Limage d'anus et éjaculation faciale pour Bree Olson
Rendez vous aux toilettes pour une partouze - Video porno films xxx sexe en streaming
Sublime brunette se fait prendre contre le bureau en casting
Renata Fox joue bien avec son gode préféré
Une mamie se tape un homme masqué dehors
Bella, Diego Rodrigues et Paox Lenehan dans une vidéo
Brooke Belle et Mia Lelani baisent en trio - Video porno films xxx sexe en streaming
Massage Erotique Saone Et Loire
Séance de sexe dans l’examen final avec l’enseignant Lena Paul
Jouant une fois de plus avec sa chatte
Magical Girl Yuni Defeat!
Petite bite se fait sucer par sa grosse femme l'aide d'un vibreur
Une fille gothique en chaleur qui baise
Jeune chatte poilue et humide
seins en forme de poire je les boufferai bien
Deux belles blondes s'amusent ensemble
Jeu magnifique blonde avec une queue en POV
Dans ce couple, c’est lui qui se fait enculer !
Angelina Rose et une copine pour des coups de langue
Brooklyn Lee se fait détruire le cul par une bite noire
Ce mec musclé satisfait cette coquine salope
Caméra cachée dans un vestiaire de femmes...
Actrice Porno Gros Seins Naturel
Un beau massage
Une étudiante chaude baise avec son prof de math
Sexe Gros Cul
Sandy procure du plaisir à Cristina Bella avec sa langue
Un papy baise une jeune blonde
Un spectacle commun
Jeune tchèque en lingerie rose
la brésilienne la veut dans les deux trous
VIDÉOS DE BELLE MÈRE FILS LES PLUS VUES
Brunette tatouée se fait défoncer par un ange déchu
Démonter une fille aux gros seins
Masturbation Orgasme
Elle se fait violer en bande et leur coupe la bite
Janet Mason une grosse queue pour la faire hurler de plaisir - Video porno films xxx sexe en streaming
Blonde à gros cul se prend deux bites
Une blonde et une brune font ça ensemble
Une partie de branlette gratuite avec Jana Cova
Lisa Ann s'éclate en anal Hardcore
Lesbienne Frotte
Club de nageurs asiatiques
Une jeune qui accepte de tourner une vido x et se faire enculer en change d'argent
Fellation Film
Arcadia Davida et Maleah Mai pour une baise interraciale entre lesbiennes - Video porno films xxx sexe en streaming
La séduisante Tia Layne pour une scène excitante
Un jeune couple qui prend son pied
Un bain de plaisir
Belle tudiante aux seins tout petits s'clate avec son mec
Une mtisse trs mignonne suce son copain blanc genoux pour avoir du sperme partout sur la gueule
Au plus profond de son cul
De superbes filles chaudes pour une bite
Brune avec des chaussettes hautes se fait baiser
Femme au corps de rêve sur le lit
Sabrina Sweet dans un trio champêtre en pleine nature
Ce beau brun se doigte le cul devant sa webcam
Une fille sexy dans une orgie
Ejaculation faciale sur une mature
Elle montre ses beaux seins en suçant et pinant
Alexia se laisse punir par l'homme de sa mère
Bonne bourre sur la table de billard
Une Coloc bien agréable à baiser finalement
Une blonde en détresse agréable
Ma salope au gros cul
Stevie jouit rapidement
Enculée comme une trainée sur son plumard
Agente immobilière baise son client dans la nouvelle maison
Scène en POV à la fac
Ma petite salope la prend dure
Pipe en 69 et baise Anale avec une Tranny
Striptease et masturbation d'une mère de famille
Une séance bondage avec une black
Allumer des bougies cela peut être sensuel
Mec baise une amie russe à la fac
Gorge profonde pour cette brunette en chaleur
Tasha Reign se fait bouffer le cul - Video porno films xxx sexe en streaming
Ariella ferrera and india summer - Video porno films xxx sexe en streaming
Bonnie Rotten baise hard avec Vyxen Steel
Brune se prend deux bites
Une femme mature allume le dépanneur
Brigitte Lahaie nue en train de bronzer
Une conférence avec des amis à poil
Femme Baiser Comme Une Chienne
Alysha Rylee branle la queue d'un black avec ses pieds - Video porno films xxx sexe en streaming
Salope se fait baiser dans le cul
Roxy Belle ligotée et baisée par plusieurs hommes - Video porno films xxx sexe en streaming
Sextape d'une toulousaine et un touriste
La salope en chaleur se fait sauter en plein public
Une amie de classe m'invite pour baiser
Du sexe lesbien chaud dans la baignoire
Jeune amatrice Asiatique en POV
Carly Rae fait la fête
Bestiale cette scène entre hommes !
Ma demi-soeur de 20 ans niquée par ma grosse bite
Camille Morgan et Ariel Stonem en mode lesbien
Trio à l'entrepôt





























h_374">al_c">lg_1">q_95/f2a262_67a63b40030b4bc7ac1f45a2b4375898~mv2.webp">

h_600">c_fill">g_north/v1553872105/une-vue-de-lentrepot-avant-les-travaux_6104845.jpg">










